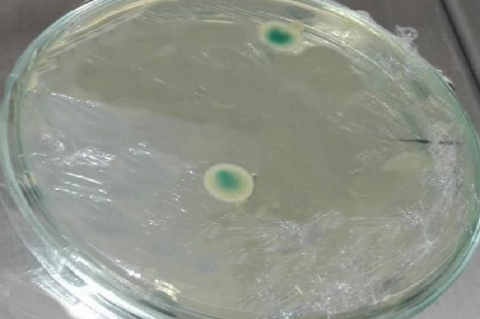

Pharmacognosy Journal,
Vol 15, Issue 4, Jul-Aug, 2023
Recent Articles
Original Article
Interaction of Masilinic Acid from Clove Plant (Syzygium aromaticum) with CD81 Antigen in Inhibiting HIV Virus Regulation In Silico
Rahadian Zainul,Elsa Yanuarti,Siti Amiroch,Muhammad Thoriq Albari,Rismi Verawati,Amalia Putri Lubis,AAA Murtadlo
Pharmacognosy Journal,15(4):484-488 DOI: 10.5530/pj.2023.15.106 Published: Mon, 14-Aug-2023 Read More
Original Article
Computational Evaluation of the Potential of Salicylate Compound from Syzygium aromaticum on Carbonic Anhydrase I as a Gastric Acid Stimulant
Rahadian Zainul,Rismi Verawati,Rauza Sukma Rita,Fadhli Ranuharja,Musa Ghufron,Agariadne Dwinggo Samala,Herland Satriawan,Muhammad Raffi Ghifari,Devi Purnamasari,Riso Sari Mandeli,Amalia Putri Lubis,Viol Dhea Kharisma,Vikash Jakhmola,Maksim Rebezov,ANM Ansori
Pharmacognosy Journal,15(4):489-493 DOI: 10.5530/pj.2023.15.107 Published: Mon, 14-Aug-2023 Read More
Original Article
In Silico Study on the Potential of Guaiacol Extract from Green Tea (Camellia sinensis) as a Stimulant for Carbanoic Anhydrase II in Renal Tubular Acidosis
Rahadian Zainul,Rismi Verawati,Agus Suprijono,Riso Sari Mandeli,Asri Peni Wulandari,Dony Novaliendry, ,Linda Rosalina,Muhammad Arya Ghifari,Amalia Putri Lubis,Viol Dhea Kharisma,Vikash Jakhmola,Maksim Rebezov,ANM Ansori
Pharmacognosy Journal,15(4):494-499 DOI: 10.5530/pj.2023.15.108 Published: Mon, 14-Aug-2023 Read More
Original Article
Molecular Docking of Thaflavine from Camellia sinensis in Inhibiting B-Cell Lymphoma Through BCl2 Apoptosis Regulator: An In Silico Study
Rahadian Zainul,Rismi Verawati,Herland Satriawan,Teresa Liliana Wargasetia,Devi Purnamasari,Amalia Putri Lubis, ,Riso Sari Mandeli,Muhammad Thoriq Albari,Viol Dhea Kharisma,Vikash Jakhmola,Maksim Rebezov,ANM Ansori
Pharmacognosy Journal,15(4):500-505 DOI: 10.5530/pj.2023.15.109 Published: Mon, 14-Aug-2023 Read More
Original Article
Study on the Inhibition of Sinensetin Extract from Cat's Whiskers Plant (Orthosiphon aristatus) on ATP Binding Cassette Sub-Family G Member 2 in Uric Acid
Anni Faridah,Rismi Verawati,Budhi Oktavia,Musa Ghufron,Devi Purnamasari,Muhammad Raffi Ghifari,Linda Rosalina,Putri Azhari,Rahadian Zainul,Viol Dhea Kharisma,Vikash Jakhmola,Maksim Rebezov,ANM Ansori
Pharmacognosy Journal,15(4):506-511 DOI: 10.5530/pj.2023.15.110 Published: Mon, 14-Aug-2023 Read More
Original Article
In Silico Study of Rhamnocitrin Extract from Clove Syzygium Aromaricum in Inhibiting Adenosine A1 Adenylate Cyclase Interaction
Nita Yessirita,Rismi Verawati,Devi Purnamasari,Rollando Rollando,Riso Sari Mandeli,Muhammad Thoriq Albari,Putri Azhari,Rahadian Zainul,Viol Dhea Kharisma,Vikash Jakhmola,Maksim Rebezov,ANM Ansori
Pharmacognosy Journal,15(4):512-517 DOI: 10.5530/pj.2023.15.111 Published: Wed, 16-Aug-2023 Read More
Original Article
Hepatitis E Inhibited by Rosmarinic Acid Extract from Clove Plant (Syzygium Aromaricum) through Computational Analysis
,Saddam Al Aziz,Fadhilah Fitri,Devni Prima Sari,Muhammad Raffi Ghifari,Rismi Verawati,Nita Yessirita,Oski Illiandri,Riso Sari Mandeli,Devi Purnamasari,Putri Azhari,Rahadian Zainul,Viol Dhea Kharisma,Vikash Jakhmola,Maksim Rebezov,ANM Ansori
Pharmacognosy Journal,15(4):518-523 DOI: 10.5530/pj.2023.15.112 Published: Wed, 16-Aug-2023 Read More
Original Article
Analysis of Lung TB Treatment Strategy in Pangkep District Year 2022
Muhammad Syafar,Ridwan Mochtar Thaha,St. Rosmanely,Rizky Chaeraty Syam,Tenri Nurafni Aprilyani
Pharmacognosy Journal,15(4):524-527 DOI: 10.5530/pj.2023.15.113 Published: Mon, 14-Aug-2023 Read More
Research Article
Phytochemical Compounds Identification From 70% Ethanol Extract of Arcangelesia Flava (L.) Merr Stems Using LC-MS/MS and In-Silico Molecular Docking Approach as Inhibitor Interleukin-1β
Rizki Rahmadi Pratama,Irawati Sholikhah, ,Ram Kumar Sahu,Retno Widyowati
Pharmacognosy Journal,15(4):528-534 DOI: 10.5530/pj.2023.15.114 Published: Mon, 14-Aug-2023 Read More
Original Article
Diversity of Types of Medicinal Plants and Local Wisdom of the Kaili Tribe in Processing Medicinal Plants Around the Forest Areas of Central Sulawesi, Indonesia
Abdul Hapid,Ariyanti Ariyanti,Erniwati Erniwati,Ni Made Dharm Suena,Ketut Agus Adrianta,Karnita Yuniarti,Muthmainnah Muthmainnah
Pharmacognosy Journal,15(4):535-540 DOI: 10.5530/pj.2023.15.115 Published: Mon, 14-Aug-2023 Read More
Original Article
Aedes Sp. Mosquito Resistance and the Effectiveness of Biolarvicides on Dengue Vector Mortality
Bambang Dwicahya,Arsunan Arsin,Hasanuddin Ishak,Firdaus Hamid,Anwar Mallongi
Pharmacognosy Journal,15(4):541-546 DOI: 10.5530/pj.2023.15.116 Published: Mon, 14-Aug-2023 Read More
Original Article
Analysis of Determinants of Midwife Performance in Antenatal Care Services in Allang Care Health Centers Central Maluku District
Josina Hattu, ,Amran Razak,Sukri Palutturi,Anwar Mallongi,Syamsiar S. Russeng
Pharmacognosy Journal,15(4):547-552 DOI: 10.5530/pj.2023.15.117 Published: Mon, 14-Aug-2023 Read More
Original Article
Expressions of Matrix Metalloproteinase-3 and Tissue Inhibitor Metalloproteinase-1 in Corneal Tissue Post Alkali Burn Treated with Topical Medroxyprogesterone Acetate and Doxycycline
Daya Banyu Bening,Reni Prastyani, ,Evelyn Komaratih,Ismi Zuhria,Hari Basuki Notobroto,Dyah Fauziah,Chrismawan Ardianto
Pharmacognosy Journal,15(4):553-557 DOI: 10.5530/pj.2023.15.118 Published: Mon, 14-Aug-2023 Read More
Original Article
Risk Analysis of Microplastic Exposure Through Consumption of Anadara Granosa at Coastal Area
Nurhayati Namira,Anwar Daud,Anwar Mallongi,Hasnawati Amqam,Atjo Wahyu,
Pharmacognosy Journal,15(4):558-562 DOI: 10.5530/pj.2023.15.119 Published: Thu, 17-Aug-2023 Read More
Original Article
Effect of Naphthaleneacetic Acid (NAA) and 6-Benzylamino Purine (BAP) on In-Vitro Propagation of "Mashua" (Tropaeolum tuberosum Ruíz & Pavón) Morphotypes from Peru
Gilmar Peña-Rojas,Luz Quispe-Calle,Vidalina Andía-Ayme,Alex Pereda-Medina,Rolando Estrada Jimenez,Josefa Bertha Pari-Olarte,Elizabeth Julia Melgar-Merino,José Santiago Almeida-Galindo,Oscar Herrera-Calderon
Pharmacognosy Journal,15(4):563-568 DOI: 10.5530/pj.2023.15.120 Published: Fri, 1-Mar-2024 Read More
Original Article
The Effectiveness of the Si-DBD Application in Increasing the Number of Households in Conducting Periodic Larvae Examination at the Health Center in Bantaeng Regency
Muhammad Firdaus,Ida Leida Maria, ,Andi Zulkifli,Nurhaedar Jafar,Shanti Riskiyani,Anwar Mallongi
Pharmacognosy Journal,15(4):569-574 DOI: 10.5530/pj.2023.15.121 Published: Wed, 16-Aug-2023 Read More
Research Article
In Silico Study on the Inhibition of Sitogluside from Clove Plant (Syzygium aromaticum) on Interleukin 2 in B and T Cell Proliferation
Linda Rosalina,Devi Purnamasari,Rismi Verawati,Okta Suryani,Muhammad Arya Ghifari,Amalia Putri Lubis,Rahadian Zainul,Riso Sari Mandeli,Viol Dhea Kharisma,Vikash Jakhmola,Maksim Rebezov,ANM Ansori
Pharmacognosy Journal,15(4):575-580 DOI: 10.5530/pj.2023.15.122 Published: Wed, 16-Aug-2023 Read More
Research Article
Interaction of Cynaroside from Orthosiphon Aristatus Plant Extract on TNF Alpha as a Stimulant in Malaria and Asthma
Rahadian Zainul,Rismi Verawati,Gemini Alam,Khoirun Nisyak,Trisna Kumala Sari,Muhammad Arya Ghifari,Ritbey Ruga,Putri Azhari, ,Himmatul Barroroh,Riso Sari Mandeli,Devi Purnamasari,Viol Dhea Kharisma,Vikash Jakhmola,Maksim Rebezov,ANM Ansori
Pharmacognosy Journal,15(4):581-586 DOI: 10.5530/pj.2023.15.123 Published: Wed, 16-Aug-2023 Read More
Research Article
Stimulation of Emodin from Aloe Vera on Protein Kinase PIM1 in the Central Nervous System Through In Silico Analysis
Rahadian Zainul,Rismi Verawati,Ritbey Ruga,Muhammad Arya Ghifari,Devi Purnamasari,Putri Azhari,Viol Dhea Kharisma,Vikash Jakhmola,Maksim Rebezov,ANM Ansori
Pharmacognosy Journal,15(4):587-592 DOI: 10.5530/pj.2023.15.124 Published: Wed, 16-Aug-2023 Read More
Research Article
Anti-inflammatory Potential of Glycoside Flavonoids from Pterocarpus erinaceus Poir. (Fabaceae) Leaves
Noufou Ouédraogo,Leila Marie Esth Belem-Kabré,A.M. Emmanuel Thiombiano,Tata Kadiatou Traoré,Lazare Belemnaba,Moussa Ouédraogo,Innocent Pierre Guissou
Pharmacognosy Journal,15(4):593-598 DOI: 10.5530/pj.2023.15.125 Published: Wed, 16-Aug-2023 Read More
Research Article
Antioxidant, Total Phenolic, and Total Flavonoid of 70% Ethanol Extract of Avocado Seeds (Persea americana Mill.)
Sri Wahyu Ning Munthe,Riskianto Riskianto,Denny Juvi,Jessica Novia
Pharmacognosy Journal,15(4):599-605 DOI: 10.5530/pj.2023.15.126 Published: Wed, 16-Aug-2023 Read More
Research Article
HPLC Isolation of Rutin, Hesperidin and Quercetin from Ruta Chalepensis Extract Growing in Iraq
Ali Mohammed Z. Al-Jaberi,Sabaa Ali Mohamm Al-Fadal,Thukaa Zuhair Abdul-Jalil,Haider Al-Wafi
Pharmacognosy Journal,15(4):606-611 DOI: 10.5530/pj.2023.15.127 Published: Wed, 16-Aug-2023 Read More
Research Article
RETRACTED: The Effects of Andrographolide on Apoptosis in PC-3 Cell Line Via the Involvement of Caspases 3, 8 And 9
Janany Manimaran,Daruliza Kernain Mo Azman
Pharmacognosy Journal,15(4):612-621 DOI: 10.5530/pj.2023.15.128 Published: Wed, 25-Oct-2023 Read More
Research Article
Community Empowerment with Independent Larva Monitor in Reducing the Dengue Hemorrhagic Fever Incidence, in Sidrap Regency
Arsunan Arsin,Ridwan Amiruddin,Dian Saputra Marzuki,Rezki Elisafitri, ,Anwar Mallongi, ,Ahmad Yani
Pharmacognosy Journal,15(4):622-625 DOI: 10.5530/pj.2023.15.129 Published: Wed, 16-Aug-2023 Read More
Research Article
RETRACTED: Human Sperm for Basic Embryo Research And 3D Treatment of Patient-Representative Ovarian Cancer Cells
Maslichah Mafruchati,Wan Irjani Wan Ismail
Pharmacognosy Journal,15(4):626-632 DOI: Published: Mon, 28-Aug-2023 Read More
Research Article
Quality of Health Services of Non-Accredited Health Centers on Patient Satisfaction
Sohordinatus Ifan Unkelefta,Amran Razak,Sukri Palutturi, ,Aminuddin Syam,Andi Ummu Salmah,Anwar Mallongi
Pharmacognosy Journal,15(4):633-640 DOI: 10.5530/pj.2023.15.131 Published: Wed, 16-Aug-2023 Read More
Research Article
Policy Implementation of Hypertension Prevention and Control Program in Banjarmasin
Sally Pobas,Balqis Nazaruddin,Sukri Palutturi, ,Syamsiar S. Russeng,Anwar Mallongi
Pharmacognosy Journal,15(4):641-649 DOI: 10.5530/pj.2023.15.132 Published: Wed, 16-Aug-2023 Read More
Research Article
The Influence of Work Engagement on Job Satisfaction and Human Resource Performance in South Sulawesi Provincial Hospital 2022
Nurfhadila Utami Husain,Syahrir A. Pasinringi,Fridawaty Rivai,Noer Bahry Noor,Khalid Saleh
Pharmacognosy Journal,15(4):650-654 DOI: 10.5530/pj.2023.15.133 Published: Wed, 16-Aug-2023 Read More
Research Article
Quantitative Analysist of Ethnomedicinal Practice and Used by the Banceuy Tribe in Subang Village of Indonesia
Marisca Evalina Gondokesumo,Silmi Qurrotu Aini,Siti Rahmadani
Pharmacognosy Journal,15(4):655-667 DOI: 10.5530/pj.2023.15.134 Published: Wed, 16-Aug-2023 Read More
Research Article